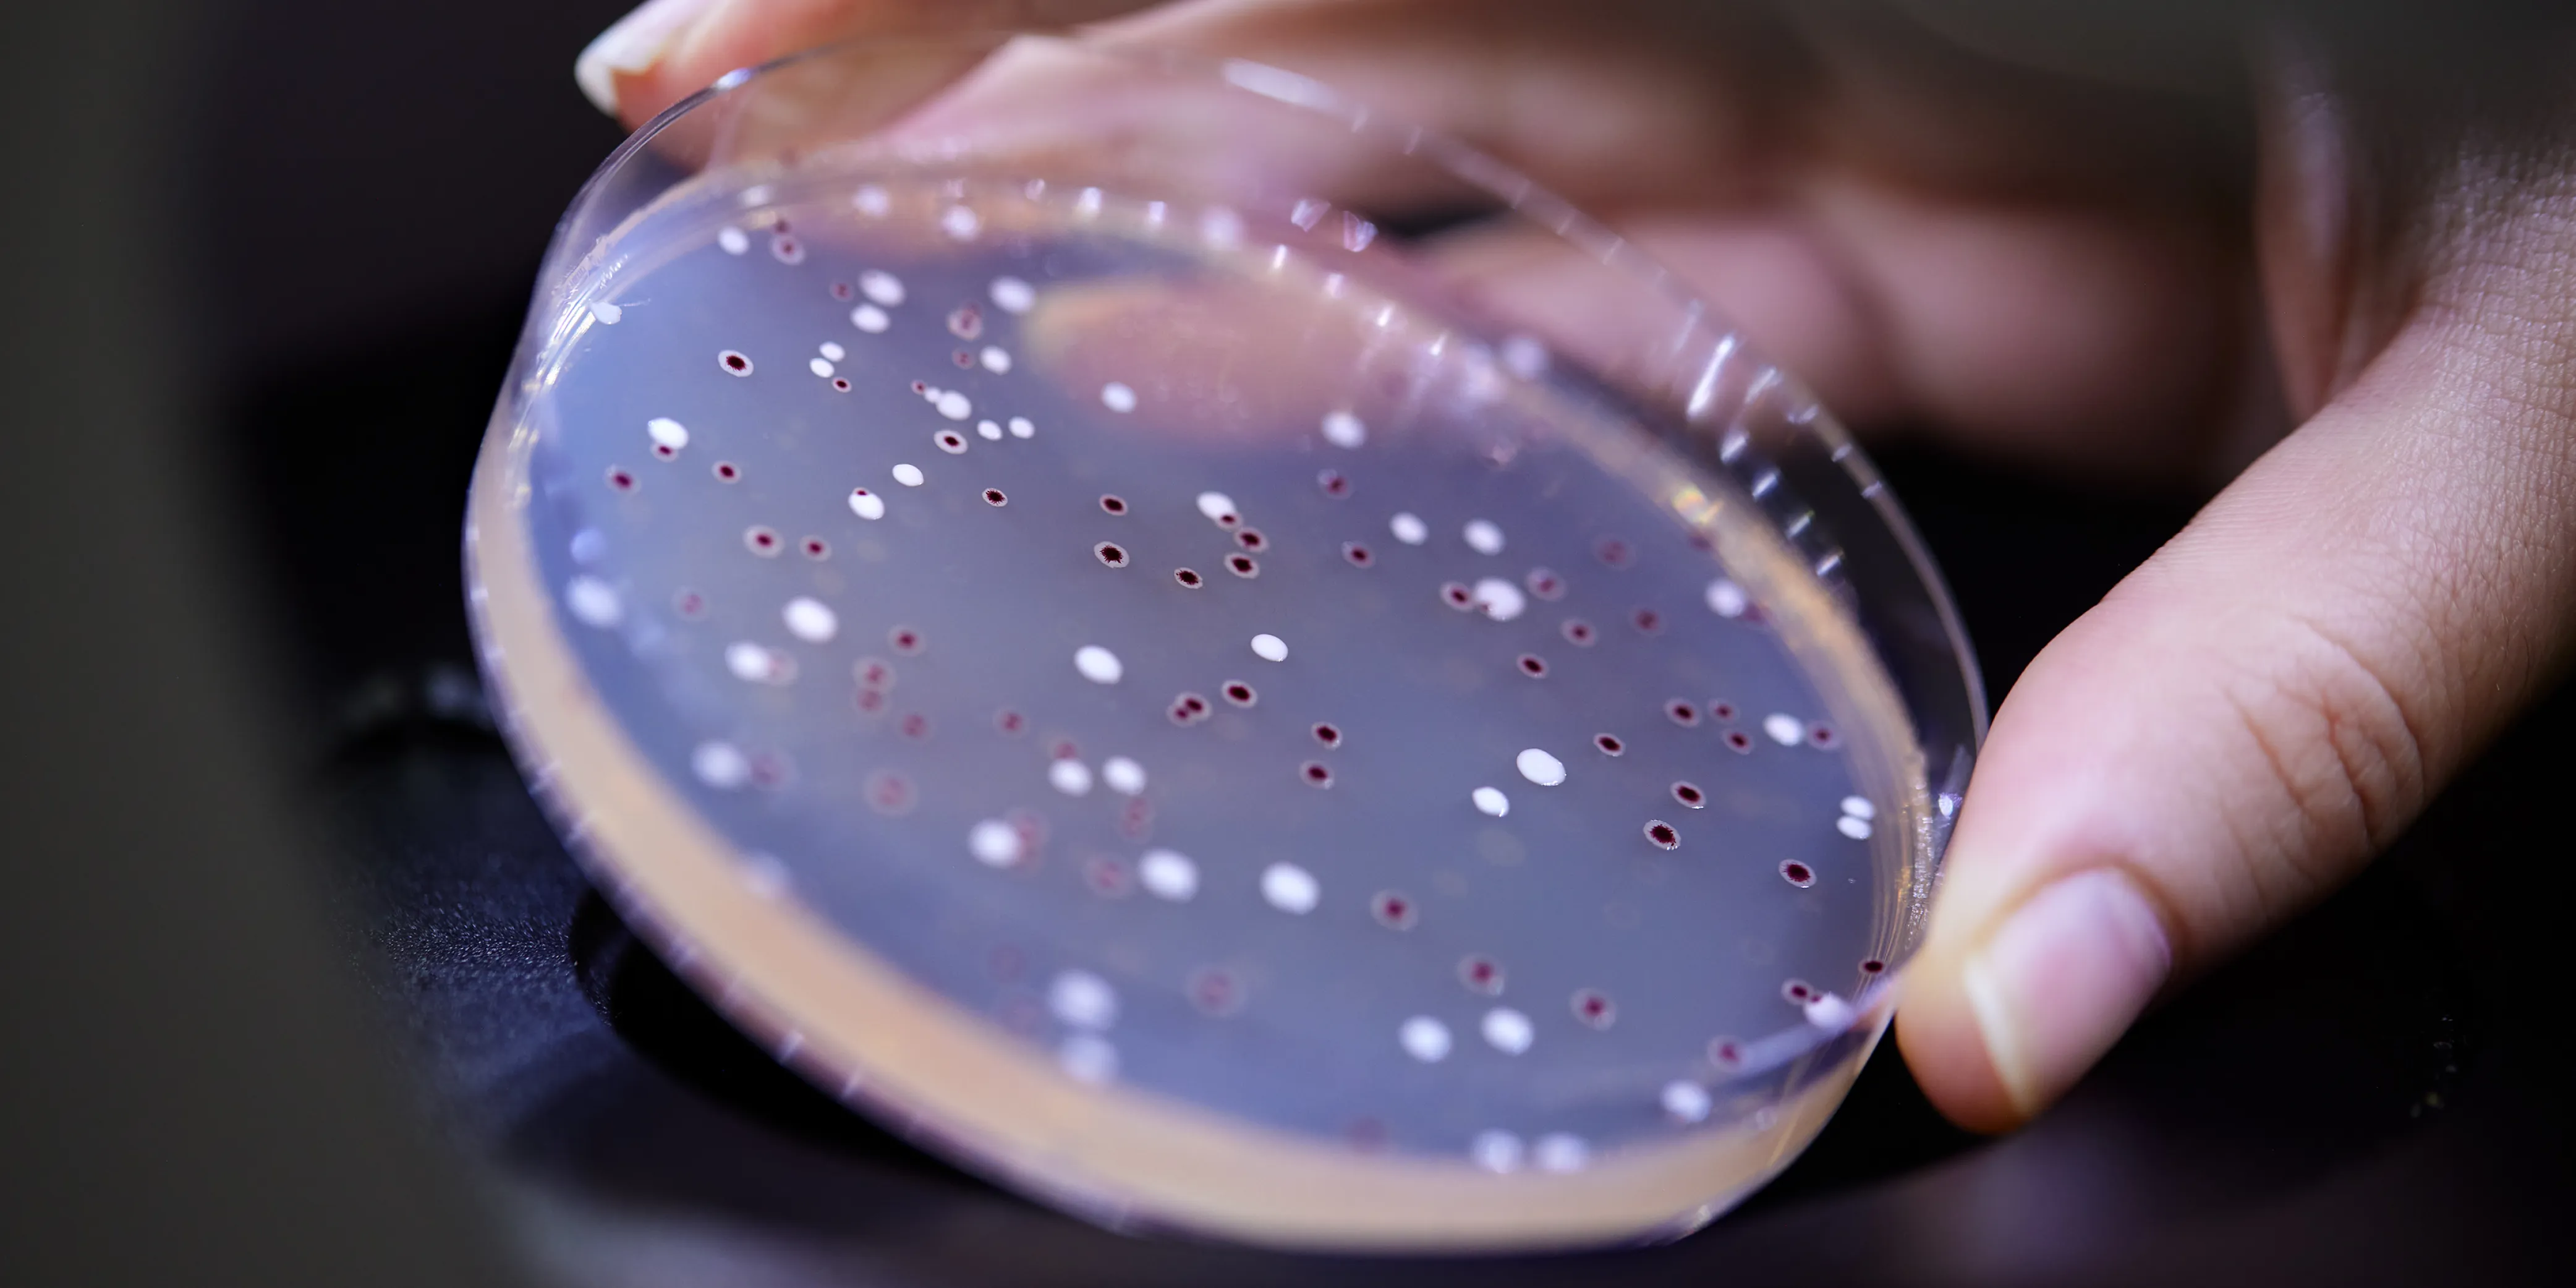
Science

Don't miss our latest pressreleases: Probi advances sports nutrition with new LP299V® clinical insights + Symrise presents Health Active & Probi® portfolios at Vitafoods Europe to deliver science‑backed wellness solutions
We’re live at Vitafoods Europe in Barcelona, May 5-7! Visit us at booth 3A88 to explore our latest innovations. Don’t miss the chance to book a meeting with our team!

Probi participates in key tradeshows, conferences, and networking events across the globe. These gatherings give us the opportunity to present our latest research, showcase our solutions, and discuss industry trends with partners and peers.
Explore our event calendar to see where you can meet the Probi team next:
We’re heading to Vitafoods Europe in Barcelona, May 5-7! Visit us at booth 3A88 to explore our latest innovations. Don’t miss the chance to book a meeting with our team via the event app or via the form below. Let’s connect, share insights, and discover new opportunities in the health and wellness space.
Vitafoods Europe
We’re eager to exhibit for the first time at the National Animal Supplement Council’s annual conference in Phoenix, AZ, May 19-21. As a recently qualified preferred supplier, we look forward to showcasing our probiotic offerings to the animal supplement industry.
2026 NASC Annual Conference
We’re proud to sponsor Probiota Americas in Vancouver, June 8–10! Join us at the event to explore the latest innovations in biotics. Organized by NutraIngredients, this is the must-attend event for anyone invested in the future of probiotics, prebiotics, postbiotics, and the microbiome. We will of course be there!
Probiota Americas
We’re excited to join HNC 2026 / Healthplex 2026 in Shanghai, June 15–17, sharing a booth with our distributor CNP. Visit us, connect with our team and learn about our latest biotic innovations and partnership opportunities. See you there!
HNC Expo
We’re attending the 19th International Scientific Conference on Probiotics, Prebiotics, Gut Microbiota and Health (IPC 2026) in Kraków, Poland, June 22–24. Join us to connect with peers, explore cutting‑edge science, and engage in networking opportunities across three days of presentations and discussions. We look forward to impactful conversations that drive the future of probiotics and microbiome research.
IPC 2026
We’re proud sponsors of the NBJ Summit, July 27–30, in Rancho Palos Verdes, CA, and are looking forward to networking with executive level players in the global supplement and nutrition industry. Connect with the Probi and Symrise leadership team there!
NBJ Summit
Would you like to meet us at an upcoming event? Please fill in your details below and let us know which event you’ll be attending in the message field